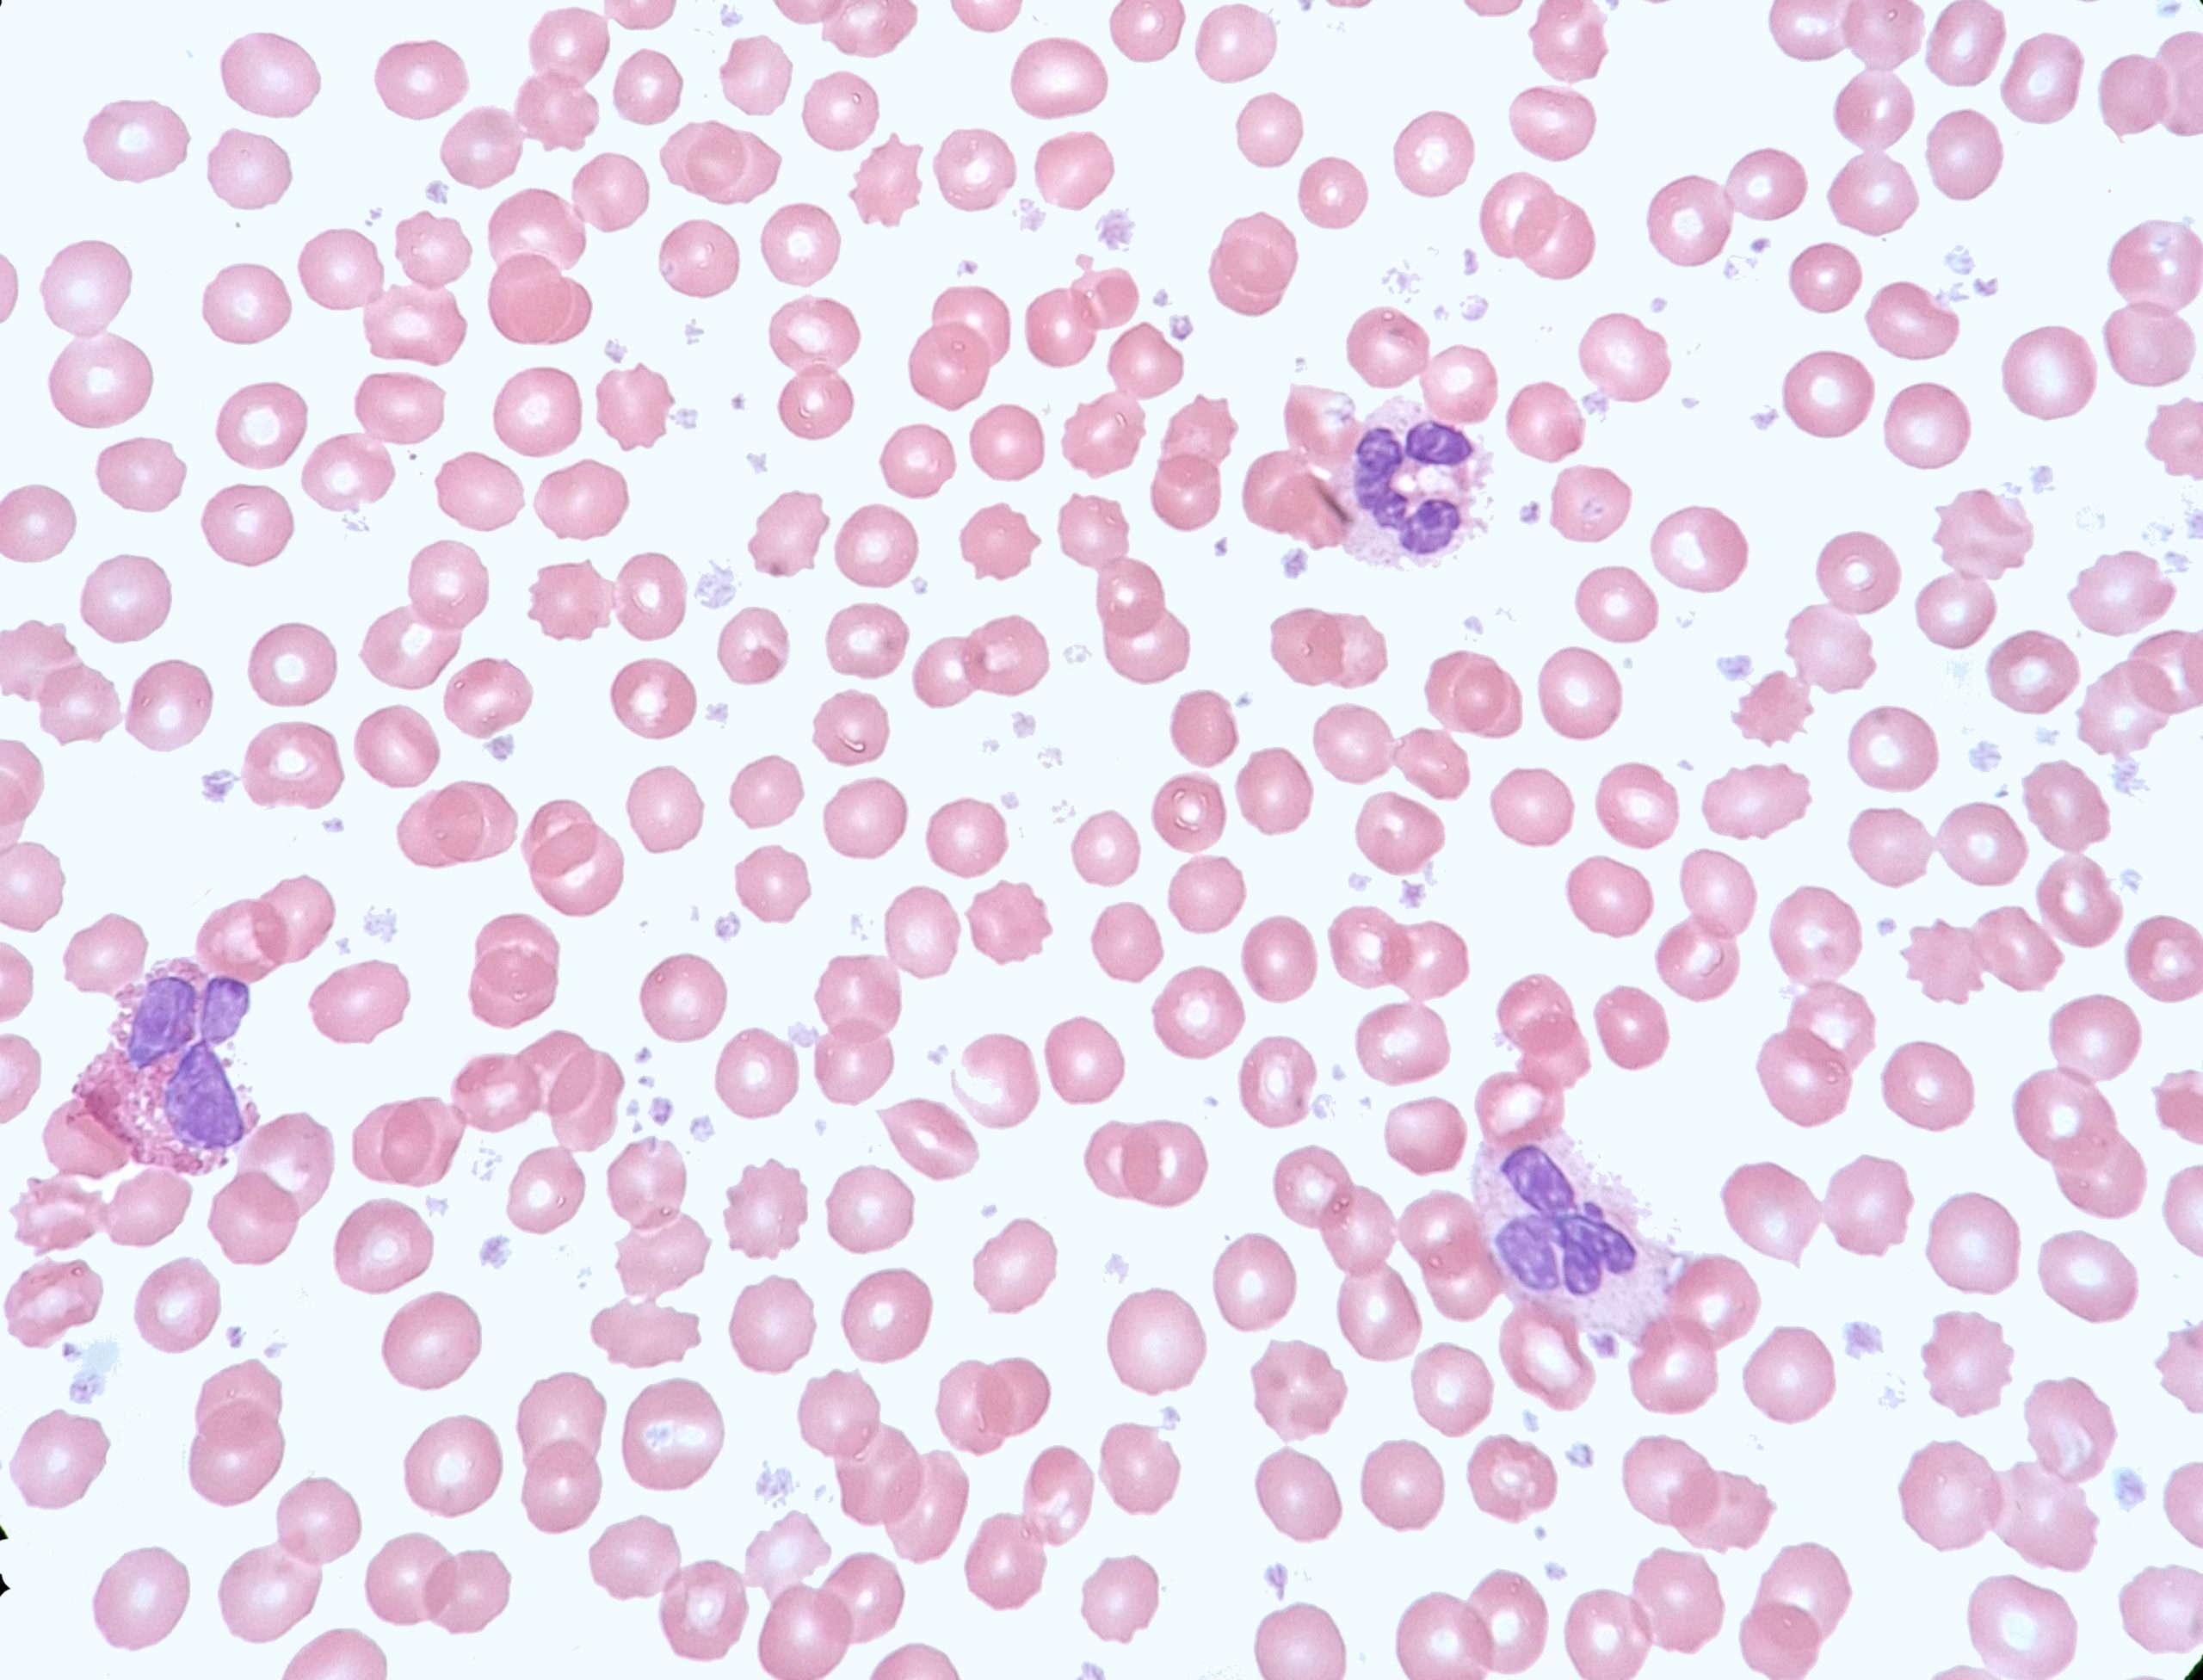

Case Presentation: This case highlights a 31-year-old female who presented with severe post-prandial abdominal pain and night sweats who was identified to have marked thrombocytosis (2.5million) with only a mild leukocytosis(20K). The patient was admitted to the hospital for urgent evaluation given the risk of untreated extreme thrombocytosis. A bone marrow biopsy was conducted which demonstrated micro megakaryocytes, characteristic of CML(Chronic Myelogenous Leukemia). Her blood was positive for the BCR-ABL fusion protein, and she was diagnosed with CML. During admission, the patient experienced an under-appreciated complication of extreme thrombocytosis – prolonged bleeding from her biopsy site due to acquired Von Willebrand deficiency. After resolution, the patient was started on Dasatanib daily therapy and her blood counts readily started to improve. Her abdominal pain resolved once platelet levels lowered with therapy.
Discussion: Chronic Myelogenous Leukemia (CML) belongs to the spectrum of diseases known as myeloproliferative neoplasms. The disease occurs when a break in chromosome 9, fuses with chromosome 22, to form what is known as the BCR-ABL gene, or Philidelphia Chromosome. This abnormal chromosomal expression typically leads to marked leukocytosis (100K+) and neutrophilia, and may be accompanied by a mild increase in platelet count. Rarely do patient’s present with extreme thrombocytosis with minimal leukocytosis. It has been readily described in literature that marked thrombocytosis can lead to neurologic symptoms, such a migraine like headaches. While our patient experienced headaches, her abdominal exam and post-prandial pain was a novel finding and reminiscent of intestinal angina — concerning for transient microvascular gut ischemia. A novel symptom presentation for CML. [1] This case highlights many of the potential sequelae to be aware of regarding management of extreme thrombocytosis from a hospitalist stand-point. To begin, when platelet levels exceed >1million, the body enters into a state of relative deficiency of VWf as platelet levels far exceed the sustainable concentration of VWf in the human body. Our patient had to return to the hospital due to prolonged bleeding from her biopsy site, and while she remained hemodynamically stable this highlights the potential risk of detrimental bleeding that could be sustained if patient were to need to undergo a procedure or were to experience an injury before the platelets return to safer levels. [2]
Conclusions: Severe abdominal pain secondary to marked thrombocytosis as a sole presenting complaint related to CML has not been well described in the literature and based on our research represents a novel presentation this disease process. This case also highlights the dangerous consequences of elevated platelets, such as prolonged and potentially fatal bleeding. This of readily recognizing CML as an etiology of CML by hospitalists so that the proper specialists can be consulted and treatment began as soon as possible.